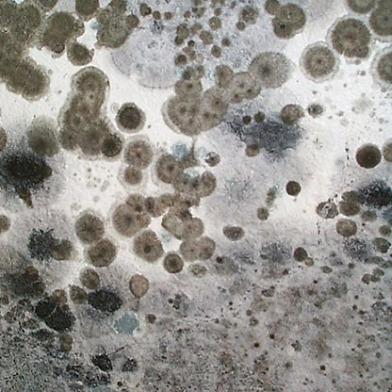
mold

by Dave Crow
October 14, 2009
Just three days after the Appeal launched, commenter Generic said that a “How Not To Get F….. By Your Landlord” column would be “awesome.” And since that day I’ve been searching for the perfect person to write such a column — and found that in Dave Crow, a lawyer who specializes in SF tenants’ issues*. Dave’s here to answer your questions every Wednesday, so send them to him at tenant@sfappeal.com – EB
I live in the Panhandle area in a 6-unit building. My apartment building has some serious temperature and mold issues.
Our common entryway has a broken skylight that leaks every time it rains. The first floor rug is now discolored and smells of mold. The landlord insists he’s “done as best he can” to fix the leak.
All of the units’ bedroom closets have huge mold problems on the walls. The landlord’s best response is to just to keep bleaching the walls. Other areas of each apartment have mold the landlords only “solutions” are to cover the areas over with paint or tile.
The building’s steam heat works inconsistently. The timer doesn’t seem to be working correctly. The windows don’t seal properly or have chunks of wood missing from the base. When tenants complain of the cold, the landlord’s only response to this is to apply cheap foam weather stripping (that’s since fallen off) to the windows.
For what we pay, we shouldn’t have heat or mold issues. So my question is, besides putting our own money into the building, can we as tenants do anything to turn our building around and into shape?
Dear Wet, Cold and Moldy in the Panhandle,
As I write this, the first big storm of the season has begun. It’s time for you and your fellow tenants to get proactive. I get the sense that everyone in the building is fed up and that you might be able to work together as a team. That’s great. Remember, there is safety in numbers.
The landlord says he’s “done as best as he can.” What is he–a four-year-old at a Berkeley T-Ball tournament? Shall we give him a trophy just for showing up? This is the type of landlord I like to call a Cheese Ball, a cheap buffoon who thinks he can own an apartment building, take all the tax deductions, collect the outrageous rent and not spend a dime to maintain it. Oh, he’ll bitch and moan about rent control and whine about all the labor he’s expended, but you must understand that this Cheese Ball wouldn’t maintain his property if he could charge $10,000.00 a month per unit and he would never pay a professional to fix anything. I can go on and on, but maybe I should answer your questions.
The landlord is breaching the implied warranty of habitability in your lease. The landlord has the duty, even if it is not in the lease, to provide you with a “habitable” unit. California Civil Code §1941.1provides a long list of characteristics of a unit that make it “untenantable” or uninhabitable.
Roof leaks and the problems caused by them, i.e. mold, cracked paint, and of course, water dripping inside are usually clear and substantial breaches. (Civil Code §1941.1[a]) The problems you describe indicate a more general roof problem than just the skylight. While mold and mildew occur frequently in bathrooms without roof leaks, the closets are a tip-off to me.
Remember, you pay your rent in exchange for the landlord providing a service, nothing more or less.As a former housepainter I know that you cannot just paint over mold and mildew; it grows through the paint. And even if you kill the mold, it will return if the roof has not been adequately repaired.
Windows that rattle and leak air and, as you indicated in the unpublished part of your letter, sills that are rotted off are also violations of Civil Code 1941.1(a). Cheap foam insulation doesn’t count as repair.
Finally inadequate heat is a violation of Civil Code 1941.1(d). San Francisco Housing Code §701(c) also requires that a permanent heating source be provided that is capable of maintaining a temperature of at least 68 degrees Fahrenheit in all habitable rooms, excluding bathrooms and hallways. The Housing Code specifically requires this level of heat to be provided 13 hours a day, from 5 AM to 11 AM and also from 3 PM to 10 PM. See Rent Board Topic No. 257
All right, now you know that it’s likely the landlord violated the law. What do you do about it? Normally I would suggest you write your landlord a letter outlining all of the problems and asked him to fix them in a short period of time, preferably not before the next ice age. BTW, if you haven’t already done so, begin to communicate with the landlord only in writing. Even if he can’t read, he will understand that your relationship has changed.
But in this case, Mr. Cheese Ball has already been notified. He’s done his best. Make a list of everything that seems questionable, call a housing inspector from the SF Department of Building Inspection and arrange a time for the inspector to visit all six units and all the common areas. Show the inspector everything. If the roof is accessible, cajole them to go up there or refer to another inspector who will. Also check to see if the building has complaints or violation from the past.
The DBI will issue a notice of violation (NOV) for the various issues and require the landlord to repair them in thirty days. You now have good evidence to use when you file a petition at the Rent Board to reduce your rent due to a substantial decrease housing services or suing the landlord in superior court for breach of the warranty of habitability.
You and all of your fellow tenants at the building should join the San Francisco Tenants Union. They can provide more specific counseling based on the facts of your situation.
Remember, you pay your rent in exchange for the landlord providing a service, nothing more or less. If he gets pissed off because you make him do his job, it’s his problem. Don’t let him make it yours. Good luck.
Note – Information on Riverstone Residential knowingly exposing tenants to extreme amounts of mold toxins at Toxic Mold Infested Jefferson Lakes Apartments in Baton Rouge, Louisiana. katy
Toxic Mold Infested Jefferson Lakes Apartments managed by Riverstone Residential
Riverstone Residential Litigation